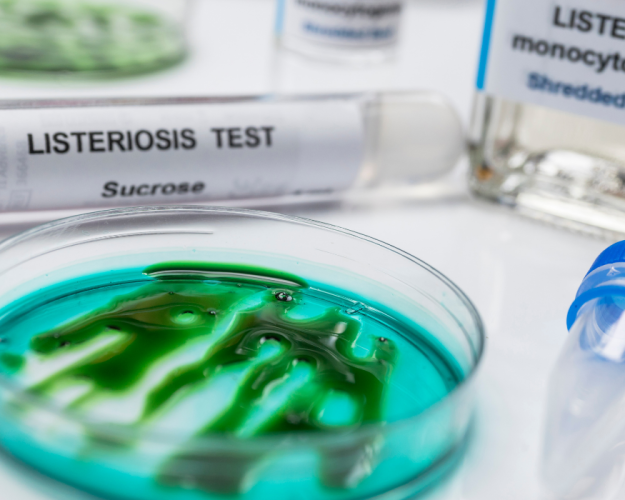

Warum sind Challengetests mit Listeria monocytogenes erforderlich?
24.10.2025
Warum sind Challengetests mit Listeria monocytogenes erforderlich?
Durch Challengetests erhält man eine Aussage darüber, ob sich Listeria monocytogenes in einem Lebensmittel vermehren können oder nicht.
Besonders gegenüber Listeria monocytogenes risikobehaftete Produkte sind z.B. Weichkäse, Rohwürste (z. B. Mettwurst) und Brühwurstaufschnitt, geräucherte oder gebeizte Fischprodukte (z. B. Lachs, Forelle) oder Rohkostsalate und vorgeschnittenes Obst.
Die Aussage, ob ein Lebensmittel das Wachstum von Listeria monocytogenes begünstigen kann oder nicht, ist aus zwei Gründen für Hersteller sehr wichtig:
- Im Rahmen seiner Sorgfaltspflicht muss jeder Lebensmittelunternehmer sicherstellen, dass seine Produkte bis zum Ende der Haltbarkeit keine Gesundheitsgefahr im Sinne von Artikel 14 der Lebensmittel-Basisverordnung (EG) 178/2002 darstellen. Da Listeria monocytogenes in der Umwelt weit verbreitet ist, kann man bei der Herstellung vieler Lebensmittel eine Kontamination mit diesen Bakterien nicht vollständig ausschließen. Umso wichtiger ist es zu wissen, ob sich Listeria monocytogenes in diesen Lebensmitteln im Laufe der Haltbarkeit auch vermehren können. Wenn die Vermehrung von Listeria monocytogenes begünstigt wird, muss das Hygiene- und Sicherheitsniveau bei der Herstellung noch höher sein.
- Die Verordnung (EG) Nr. 2073/2005 über mikrobiologische Kriterien fordert im Anhang I, Kapitel 1 die Einhaltung bestimmter Lebensmittelsicherheitskriterien für Listeria monocytogenes. Diese Kriterien müssen von Lebensmittelunternehmer genau beachtet und eingehalten werden.
Im zweiten Teil werden wir uns mit der Kategorisierung 1.2 und 1.3 des Anhangs I, Kapitel 1 der Verordnung (EG) Nr. 2073/2005 sowie mit den damit einhergehenden Nachweispflichten der Lebensmittelunternehmer, u.a. der Durchführung von Challengetests befassen.
Unseren Steckbrief zu Listeria monocytogenes finden Sie wichtige Informationen.
In unseren Tentamus-Laboren führen wir die Untersuchungen auf Listeria monocytogenes sowie Challengetests mit Listeria monocytogenes regelmäßig durch. Wir liefern Ihnen schnelle und zuverlässige Ergebnisse.
Für Fragen stehen Ihnen unsere Kundenberater sehr gerne zur Verfügung.
Weitere Links:
- BfR - Bundesinstitut für Risikobewertung: www.bfr.bund.de
- RKI – Robert-Koch-Institut: www.rki.de
